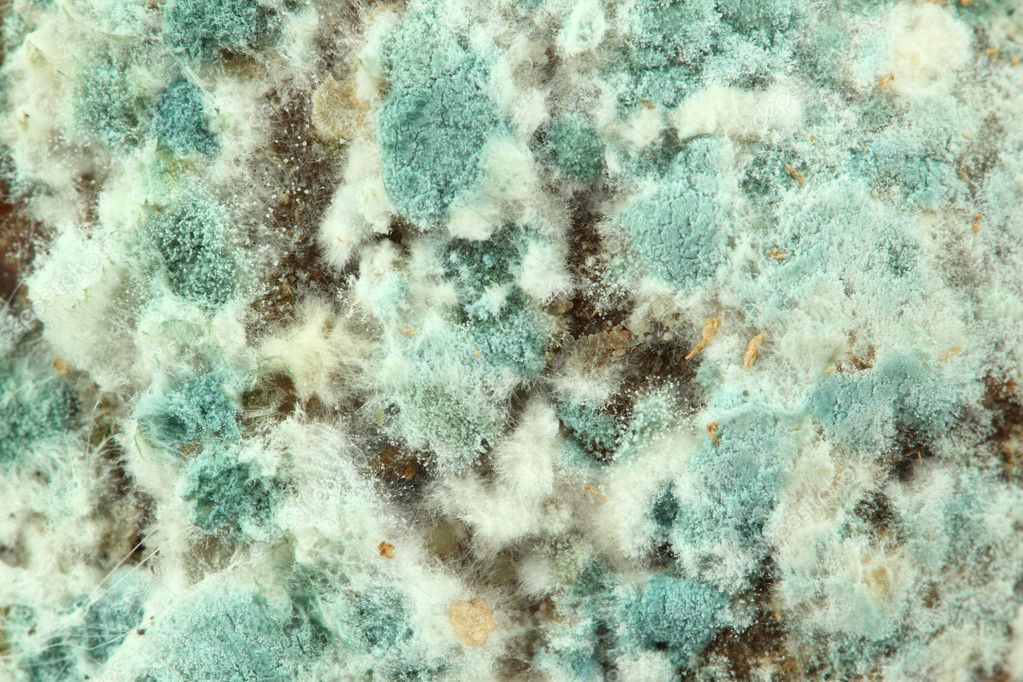

Mold Remediation Certification Online
Here are some of the images for Mold Remediation Certification Online that we found in our website database.

Penicillium Mold In Homes

Bread Mold Beautiful Mold Mold Spores Macro Mold is Light Yellow

10 Ways of Dealing with Mold Brickley Environmental

What You Need to Know About Mold National Disaster Recovery

Surprisingly Beautiful Time Lapses of Mold Growing

What Is the Difference Between White Green Mold? Sciencing

Mildew vs Mold: How Each Can Harm Your Health

Mold Things You Need to Know SERVPRO of Seattle Northeast
Mold closeup Stock Photo © nikkytok #10232393

Different Kinds Of Mold On Food

Mold Overview PowerVacAmerica

4 Ways Mold Can Impact Your Health Medium

What is Mold? ApartmentGuide com

Difference Between Mold and Black Mold Definition Features Health

The Best Way To Remove Mold And Mildew Off Of All Your Patio Furniture

Mold Environmental Standards Inc

Learn Some Mold Facts to Better Protect Your Home and Family

Mold Growth and Mold Remediation in Buildings National Disaster Recovery

Is Mold Dangerous To Your Health Exposure Risks Dangers

Everything You Need To Know About Mold And Your Home Dc Water Restoration

What is Mold?

Mold

It s black mold right? : r/HomeMaintenance

Five Questions on Mold and Food Safety The Fermentation Podcast

5 Signs of Mold in Your Home

Mold On Clothes

Is Mold In Your Cab A Threat To Your Health? CDLLife

Opiniones de mold

black mold Nutrition with Beth

Common Areas for Mold Growth HGTV

Topics on Mold Testing and Mold Symptoms Mold Test Company

Mold

About Mold

11 Types of Mold and What to Look For Professional Service